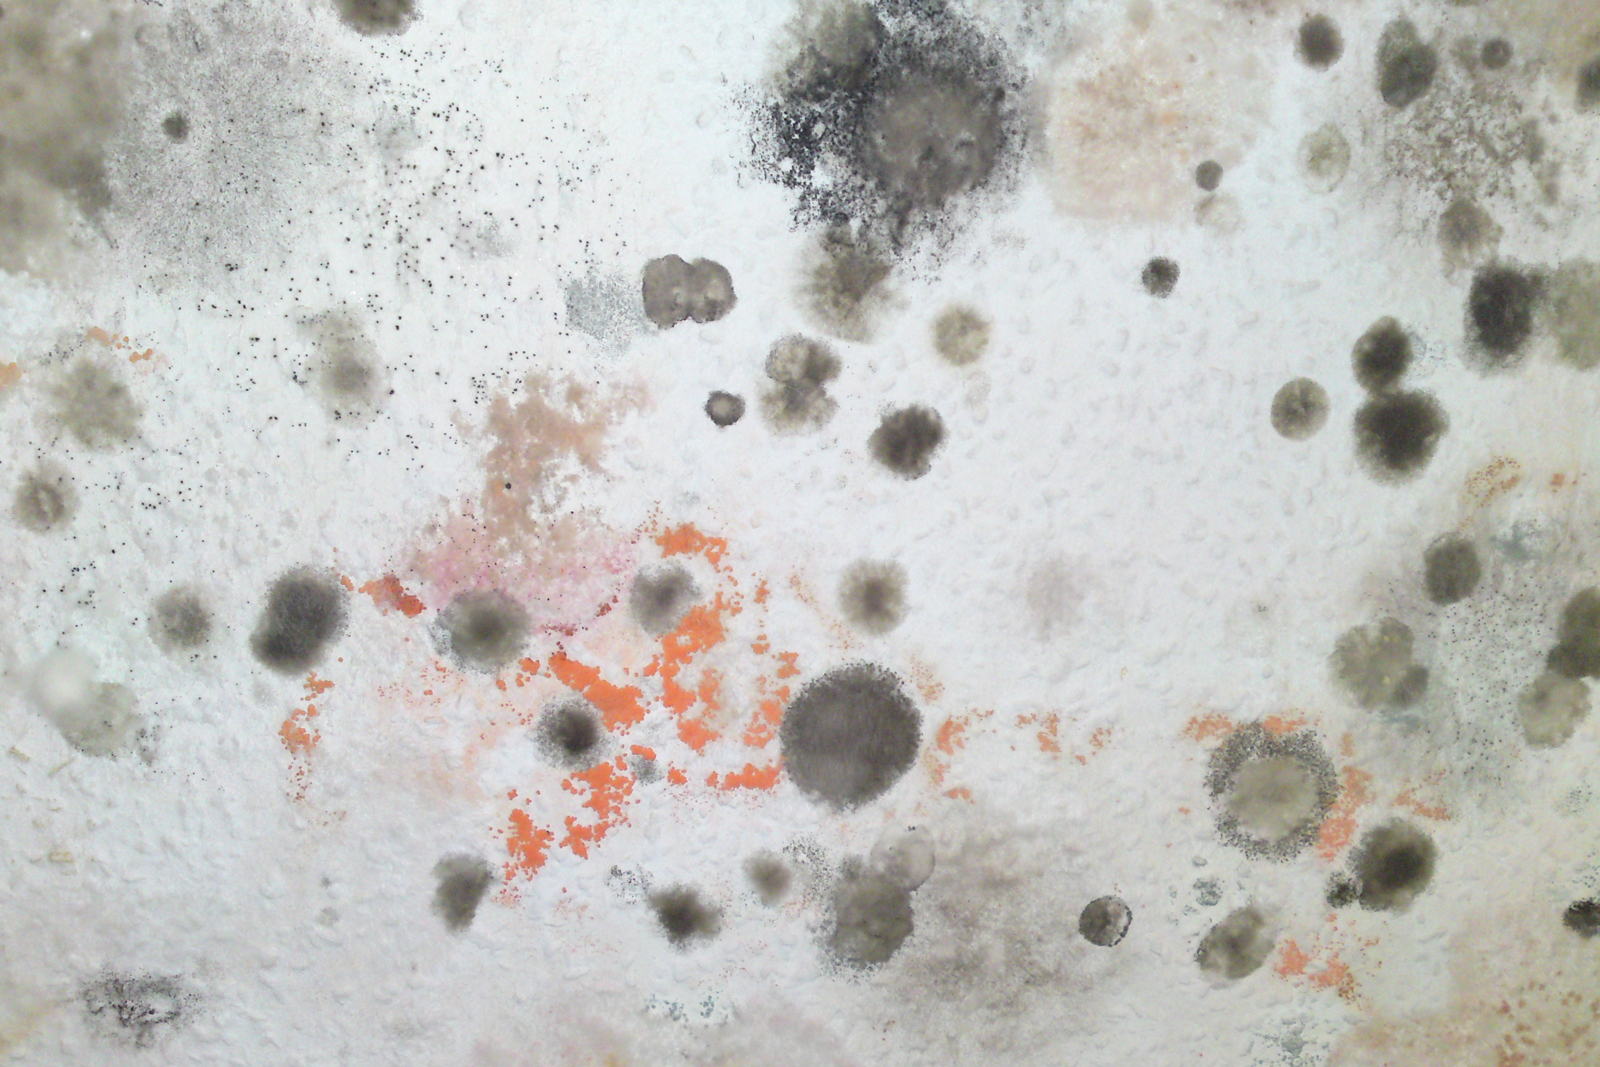

Anzeichen von eindringender Nässe
Vor jeglichen Behandlungen von Feuchtigkeitsschäden an Mauerwerk, sollte immer die genaue Ursache des Problems identifiziert werden. Um die genaue Ursache des Wassereindringens zu identifizieren, sollte am besten eine volle Untersuchung des Mauerwerks durch einen Sachverständigen vollzogen werden.
Rufen Sie uns unter 04087407563 an oder senden Sie uns eine Nachricht für Kontaktdaten von Sachverständigen in Ihrer Nähe.
Auswirkungen von eindringender Nässe an Außenmauern

Auswirkungen von eindringender Nässe sind oft an Außenmauern sichtbar. Beschädigte Ziegelsteine, Moos- und Algenwachstum, sowie lokale feuchte Stellen am Mauerwerk sind häufige Anzeichen von eindringender Nässe.
Beschädigte Ziegelsteine

Beschädigte Ziegelsteine sind oft ein Anzeichen von eindringender Nässe im Mauerwerk. Oftmals verursacht Frost Abplatzungen an den Ziegelsteinen. Wasser dringt in das Mauerwerk ein, dehnt sich während des Gefrierens aus, und verursacht so Schäden im Mauerwerk.
Moos- und Algenwachstum an Außenmauern

Nasse Wände bieten oft einen idealen Nährboden für Moos und Algenwachstum. Diese Organismen gedeihen besonders auf nassem Untergrund und können sich weit verbreiten. Nasse Wände garantieren einen idealen Nährboden für Mooswachstum, und führen zu verschmutztem Mauerwerk.
Lokale feuchte Stellen am Mauerwerk

Auch das Erscheinen von lokalen feuchten Stellen am Mauerwerk ist ein Anzeichen von eindringender Nässe. Diese feuchten Stellen können in Größe variieren, je nachdem, wieviel Feuchtigkeit in das Mauerwerk eindringt.
Auswirkungen von eindringender Nässe auf Innenwände

Die Auswirkungen von eindringender Nässe sind nicht nur an Außenmauern sichtbar. Auch Innenwände können Anzeichen von eindringender Nässe zeigen, wie zum Beispiel Schäden am Putz, Verfaulen von Holz und Schimmel an Wänden.
Schäden an Tapeten und Wandanstrichen

Eindringende Nässe kann der Grund für Blasen im Wandanstrich, sich von der Wand lösende Tapete, sowie Salpeter Ausblühungen an den Wänden sein.
Holzfäule aufgrund eindringender Nässe

Nasse Wände können negative Auswirkungen auf Holzbefestigungen haben. Wasser dringt durch das Mauerwerk, tränkt das Holz und lässt dieses verrotten.
Schimmel an Wänden
Schimmel an Wänden wird häufig mit Kondensation assoziiert. Eindringende Feuchtigkeit kann jedoch auch einer der Gründe für Schimmelwachstum an Wänden sein.
Rufen Sie uns unter 04087407563 an oder senden Sie uns eine Nachricht für weitere Information über das Behandeln von nassen Wänden.


